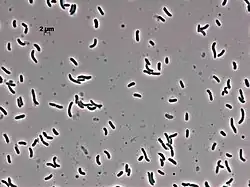

Edwardsiella anguillarum
| Edwardsiella anguillarum | ||
|---|---|---|
![]() Edwardsiella anguillarum | ||
| Taxonomía | ||
| Dominio: | Bacteria | |
| Reino: | Pseudomonadati | |
| Filo: | Pseudomonadota | |
| Clase: | Gammaproteobacteria | |
| Orden: | Enterobacterales | |
| Familia: | Hafniaceae | |
| Género: | Edwardsiella | |
| Especie: |
Edwardsiella anguillarum Shao et al. 2015 | |
Edwardsiella anguillarum es una especie de bacteria gramnegativa del género Edwardsiella. Fue descrita en el año 2015. Su etimología hace referencia a anguila.[1] Es móvil por flagelación perítrica. Tiene un tamaño de 0,6 μm de ancho por 1,4-1,5 μm de largo. Catalasa positiva y oxidasa negativa. En agar TSB, forma colonias grises, con márgenes irregulares. Temperatura de crecimiento entre 18-37 °C, óptima de 28-30 °C. Con las nuevas técnicas moleculares, se ha observado que muchos aislamientos antiguos de esta especie se identificaron como Edwardsiella tarda. Se ha aislado de anguilas enfermas y de otros peces.[2][3]
Enfermedad en peces
Puede causar infecciones principalmente en anguilas, aunque también en otros peces. Además, se han descrito varios brotes en criaderos.[4][5] En anguilas, los síntomas típicos que causa son cabeza roja, agrandamiento del hígado, congestión, enrojecimiento de la aleta pectoral, la glútea y la abdominal. En estudios de patogenicidad ha mostrado una dosis letal 50% de 5,7.102 unidades formadoras de colonias en rodaballo, mostrando ser más patógena en este pez que en anguilas y peces cebra.[1] En uno de los estudios se aisló una cepa patógena que no presentaba flagelos, debido a una deleción de 36 nucleótidos en los genes flagelares.[5] De esta misma cepa también se aisló un profago.
Se encuentran en estudio vacunas contra E. anguillarum en anguilas, utilizando el antígeno OmpA, que han mostrado una tasa de supervivencia del 83% en anguilas japonesas (Anguilla japonica) y del 55% en anguilas europeas (Anguilla anguilla).[6][7]
Referencias
- ↑ a b Shao, Shuai; Lai, Qiliang; Liu, Qin; Wu, Haizhen; Xiao, Jingfan; Shao, Zongze; Wang, Qiyao; Zhang, Yuanxing (2015-02). «Phylogenomics characterization of a highly virulent Edwardsiella strain ET080813(T) encoding two distinct T3SS and three T6SS gene clusters: Propose a novel species as Edwardsiella anguillarum sp. nov». Systematic and Applied Microbiology 38 (1): 36-47. ISSN 1618-0984. PMID 25466920. doi:10.1016/j.syapm.2014.10.008. Consultado el 17 de agosto de 2022.
- ↑ Elgendy, Mamdouh Y.; Sherif, Ahmed H.; Kenawy, Amany M.; Abdelsalam, Mohamed (2022-08). «Phenotypic and molecular characterization of the causative agents of edwardsiellosis causing Nile tilapia (Oreochromis niloticus) summer mortalities». Microbial Pathogenesis 169: 105620. ISSN 1096-1208. PMID 35690232. doi:10.1016/j.micpath.2022.105620. Consultado el 17 de agosto de 2022.
- ↑ Rahmawaty, Atiek; Chen, Mei-Yun; Byadgi, Omkar Vijay; Wang, Pei-Chi; Chen, Shih-Chu (2 de agosto de 2022). «Phenotypic and genotypic analysis of Edwardsiella isolates from Taiwan indicates wide variation with a particular reference to Edwardsiella tarda and Edwardsiella anguillarum». Journal of Fish Diseases. ISSN 1365-2761. PMID 35916068. doi:10.1111/jfd.13688. Consultado el 17 de agosto de 2022.
- ↑ Armwood, Abigail R.; Camus, Alvin C.; López-Porras, Adrián; Ware, Cyndi; Griffin, Matt J.; Soto, Esteban (2019-10). «Pathologic changes in cultured Nile tilapia (Oreochromis niloticus) associated with an outbreak of Edwardsiella anguillarum». Journal of Fish Diseases 42 (10): 1463-1469. ISSN 1365-2761. PMID 31309584. doi:10.1111/jfd.13058. Consultado el 17 de agosto de 2022.
- ↑ a b Katharios, Pantelis; Kalatzis, Panos G.; Kokkari, Constantina; Pavlidis, Michail; Wang, Qiyao (2019). «Characterization of a Highly Virulent Edwardsiella anguillarum Strain Isolated From Greek Aquaculture, and a Spontaneously Induced Prophage Therein». Frontiers in Microbiology 10: 141. ISSN 1664-302X. PMC 6372524. PMID 30787917. doi:10.3389/fmicb.2019.00141. Consultado el 17 de agosto de 2022.
- ↑ Guo, Songlin; Hu, Linlin; Feng, Jianjun; Lin, Peng; He, Le; Yan, Qingpi (2019-06). «Immunogenicity of a bivalent protein as a vaccine against Edwardsiella anguillarum and Vibrio vulnificus in Japanese eel (Anguilla japonica)». MicrobiologyOpen 8 (6): e00766. ISSN 2045-8827. PMC 6562130. PMID 30444580. doi:10.1002/mbo3.766. Consultado el 17 de agosto de 2022.
- ↑ Guo, Songlin; He, Le; Wu, Liqun; Xiao, Yiqun; Zhai, Shaowei; Yan, Qinpi (2020-02). «Immunization of a novel bivalent outer membrane protein simultaneously resisting Aeromonas hydrophila, Edwardsiella anguillarum and Vibrio vulnificus infection in European eels (Angullia angullia)». Fish & Shellfish Immunology 97: 46-57. ISSN 1095-9947. PMID 31846771. doi:10.1016/j.fsi.2019.12.044. Consultado el 17 de agosto de 2022.